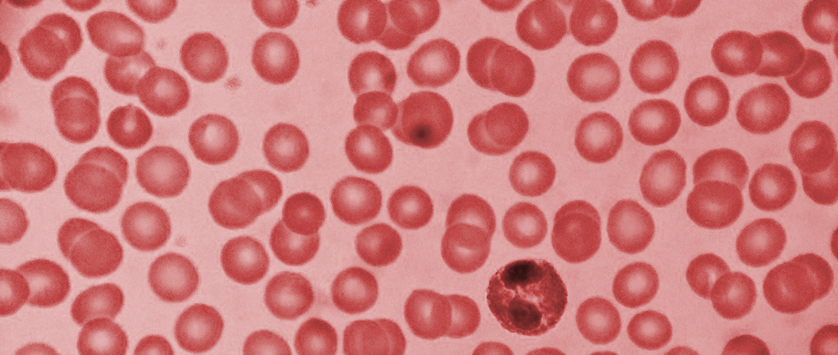
Romiplostym u chorych na zespoły mielodysplastyczne niższego ryzyka wg IPSS z małopłytkowością

U około 50% chorych na zespoły mielodysplastyczne niższego ryzyka wg IPSS stwierdza się małopłytkowość, która wiąże się ze zwiększonym ryzykiem krwawień, krótszym czasem do transformacji do ostrej białaczki szpikowej oraz krótszym czasem całkowitego przeżycia.
Materiał przeznaczony wyłącznie dla pracowników służby zdrowia
Ten materiał jest dostępny dla zarejestrowanych użytkowników.
Zaloguj się
Szanowni użytkownicy,
część materiałów udostępnianych na naszym portalu jest przeznaczona
wyłącznie dla lekarzy.
Wynika to z regulacji prawnych, do których musimy się stosować.
Jeśli nie jesteś lekarzem, zachęcamy do korzystania z przygotowanych przez nas materiałów dostępnych w zakładce dla pacjentów.